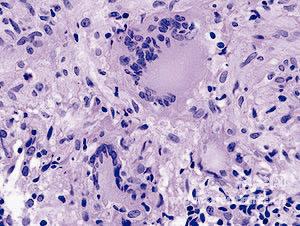

新的化合物能够有效抵抗分枝杆菌,但对哺乳动物蛋白酶体却毫发无伤。图为结核分枝杆菌。
本报讯 结核分枝杆菌所具有的进入非复制状态的能力——从而使标准抗生素无法对其产生有效影响——迫使长期治疗成为必须,进而导致病人的药物遵从性降低,而这又能够促进抗药菌株的出现。据最近出版的《自然》杂志报道,美国科学家发现,用某种化合物(oxathiazol-2-one)能够有选择地抑制分枝杆菌蛋白酶体,对于瞄准这种非复制状态非常有用,这意味着新的方法能够在发展中国家抗击这种最普遍的传染病。
分枝杆菌是已知唯一具有蛋白酶体——蛋白质联合体,能够降解被损害的蛋白质,在结构上保存于从古生菌到真核细胞的微生物中——的细菌性病原体。这种保存为研制特定种类的蛋白酶体抑制剂——即并非宿主的内生毒物——制造了障碍,然而,与哺乳动物蛋白酶体所具有的7类β-子群相比,结核分枝杆菌蛋白酶体的内核仅仅包含有一类β-子群,从而为寻找病原体的特定靶点提供了可能性。 内容来自实验室前沿网站
对两万种化合物进行的生物体外筛查鉴别出了结核分枝杆菌蛋白酶体的两种oxathiazol-2-one抑制剂,名为GL5和HT1171。当浓度为50μM时,这些化合物在1小时之内在牛型结核菌细胞中抑制了90%的蛋白酶体活性。在导致细菌休眠的相关病理状态的氧化硝基压力模型下,GL5和HT1171导致了结核分枝杆菌细胞依据浓度的致死,然而在浓度达到75μM时,它们对于哺乳动物细胞系却没有明显的毒性。这种特定种类的选择性通过动力学研究得到了证明,表明与人类蛋白酶体相比,这种抑制剂对结核分枝杆菌蛋白酶体的有效抵抗是前者的1000多倍。
利用液相色谱法——用来研究抑制机制的质谱分析方法,美国纽约市魏尔-康奈尔医学院的Gang Lin与同事发现,GL5和HT1171能够更改结核分枝杆菌蛋白酶体β-子群的氨基酸末端苏氨酸残基。通过研究结核分枝杆菌蛋白酶体的晶体结构及其与HT1171的结合,研究人员确认了抑制剂能够导致蛋白酶体的一种显著的构象变化。有证据表明,非守恒的氨基酸与用来稳定这些构象变化的蛋白酶体活性位点之间相距很远,从而可以解释为什么抑制剂能够有效抵抗分枝杆菌,而对哺乳动物蛋白酶体却是无效的。
然而许多当前可用的针对肺结核靶点核糖体的抗传染方法都依赖于分枝杆菌的复制来奏效,瞄准蛋白酶体的药物将战胜这一最主要的局限性,并为对抗肺结核流行提供更加广泛而有效的武器。(群芳) 实验室前沿,了解实验室动态

















